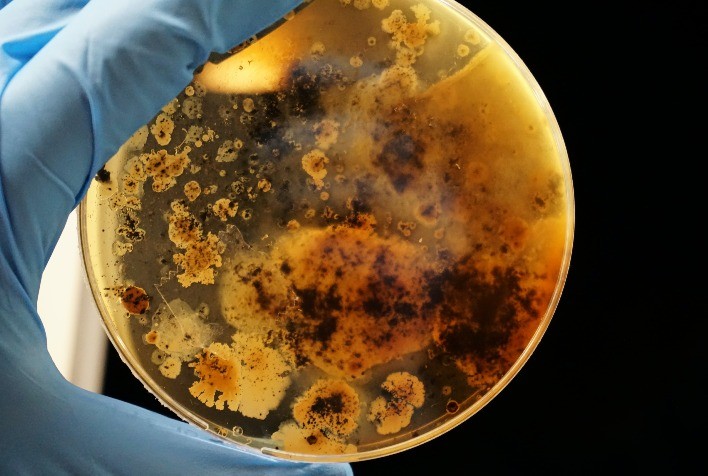
Bioinsumos impulsionam produtividade e reduzem custos no agronegócio brasileiro

Bioinsumos impulsionam produtividade e reduzem custos no agronegócio brasileiro
Tecnologias baseadas em microrganismos aumentam eficiência nutricional, reduzem uso de químicos e podem gerar economia de até US$ 5,1 bilhões por ano no campo
Publicado em: 02/12/2025 às 16:00hs
Crescimento expressivo no uso de biológicos no Brasil
O uso de bioinsumos tem ganhado força no agronegócio brasileiro, impulsionado pela busca por maior produtividade aliada à sustentabilidade. Segundo levantamento da FGVAgro, a área tratada com produtos biológicos cresceu 50% entre as safras 2021/2022 e 2023/2024.
Esses insumos, desenvolvidos a partir de microrganismos que estimulam o crescimento das plantas e melhoram a absorção de nutrientes, estão se tornando ferramentas estratégicas no manejo agrícola. Além de reduzir a dependência de químicos, os biológicos também protegem as culturas contra pragas e doenças, favorecendo o equilíbrio natural do solo.
Eficiência nutricional e redução no uso de químicos
Os produtos biológicos atuam diretamente na nutrição das plantas. Bactérias fixadoras de nitrogênio e microrganismos que facilitam a absorção de fósforo, por exemplo, ampliam a disponibilidade de macro e micronutrientes, resultando em cultivares mais vigorosas e saudáveis.
De acordo com Rafael de Souza, CEO e cofundador da Symbiomics, empresa brasileira especializada em biotecnologia agrícola, os biológicos representam “um avanço significativo na agricultura moderna”. Ele destaca que a tecnologia “permite maior aproveitamento de nutrientes e reduz a necessidade de insumos importados, diminuindo custos e fortalecendo a competitividade do agronegócio nacional”.
Pesquisas comprovam ganhos em qualidade e produtividade
Estudos internacionais reforçam os benefícios do uso de bioinsumos. Pesquisa publicada no Europe PMC mostrou que o uso desses produtos aumenta compostos antioxidantes — como antocianinas e flavonoides — e eleva o teor de minerais e clorofila em frutas e hortaliças.
Outro levantamento, publicado na revista Agriculture, apontou que biofertilizantes elevaram em média o teor de vitamina C em 14,6% e de proteína em 16,6% nas culturas analisadas na China, comprovando ganhos diretos na qualidade nutricional dos alimentos.
Diversificação e inovação em biotecnologia
Apesar de existirem desde a década de 1950, os produtos biológicos têm passado por um processo de diversificação acelerado. Dados do Ministério da Agricultura e Pecuária (MAPA) indicam que, entre 2020 e 2024, foram registrados 631 novos inoculantes, representando cerca de 87% do total disponível no país.
No Brasil, há 737 produtos registrados, sendo 62% à base de microrganismos do gênero Bradyrhizobium e 10% de Azospirillum brasilense. Para ampliar a diversidade, a Symbiomics investe em pesquisa de novos microrganismos oriundos da biodiversidade brasileira, com múltiplas aplicações para nutrição e biocontrole.
Impacto ambiental e ganhos econômicos
A adoção de biológicos também contribui para a sustentabilidade. A fixação biológica de nitrogênio em leguminosas, como soja e feijão, reduz a necessidade de fertilizantes sintéticos, cortando custos e emissões de gases de efeito estufa.
- O Brasil é referência mundial nesse campo: cerca de 90% da área de soja já utiliza inoculação com bactérias do gênero Bradyrhizobium, substituindo fertilizantes químicos em larga escala.
Segundo estudo do MAPA publicado em 2024, a ampliação do uso de bioinsumos em gramíneas — como milho, trigo e cana-de-açúcar — poderia gerar economia de até US$ 5,1 bilhões por ano e reduzir 18,5 milhões de toneladas de CO₂ emitidas anualmente.
O papel da inovação tecnológica
Para Jader Armanhi, COO e cofundador da Symbiomics, “os biológicos ganham protagonismo ao oferecer alternativas mais eficientes e com menor impacto ambiental”. Ele destaca que o objetivo da empresa é acelerar a transição para uma agricultura mais sustentável e regenerativa.
A Symbiomics tem se diferenciado pelo uso de ferramentas como sequenciamento genômico, inteligência artificial e edição de genomas na busca por microrganismos com múltiplos modos de ação. A empresa mantém uma coleção própria baseada na biodiversidade brasileira e utiliza plataformas que analisam milhares de cepas para identificar as mais promissoras em nutrição, biocontrole e sequestro de carbono.
Recentemente, a companhia firmou parcerias com Nitro e Stoller, além de concluir uma rodada de financiamento Série A liderada pela Corteva Catalyst, com participação da Arar Capital, Cazanga, MOV Investimentos e The Yield Lab Latam — consolidando sua liderança no setor e ampliando a presença no mercado nacional e internacional.
Fonte: Portal do Agronegócio
◄ Leia outras notícias